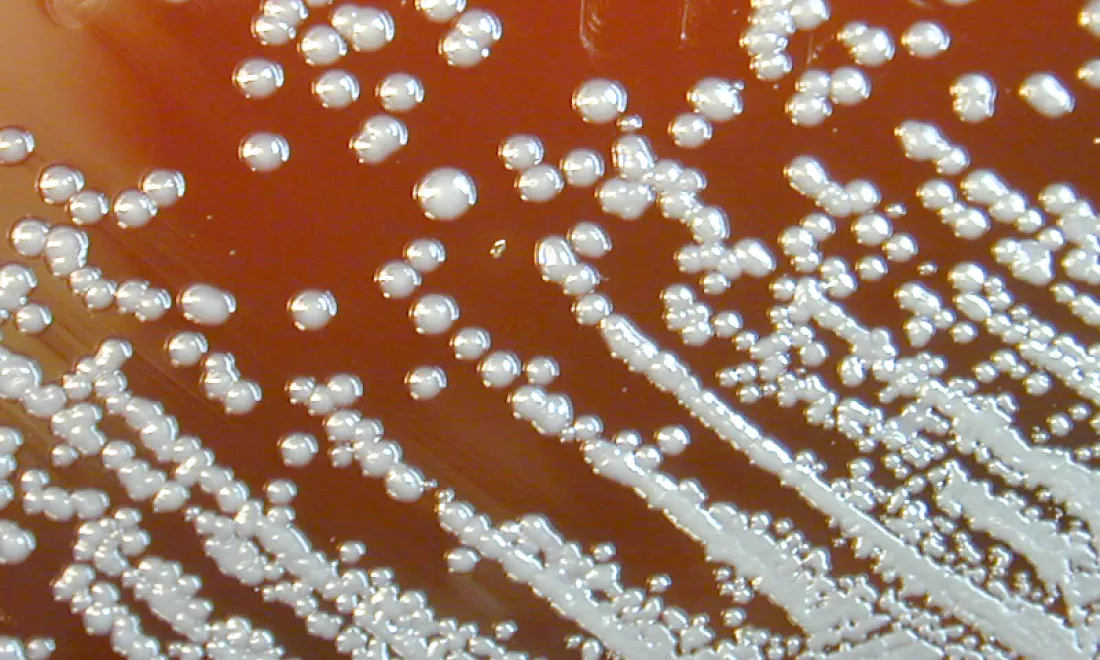
Burkholderia pseudomallei bacteria growth on a petri dish. CDC, Courtesy of Larry Stauffer, Oregon State Public Health Laboratory

IIDDO is currently scoping several new poverty-related infectious disease themes. As part of this process, IDDO conducts a scoping and feasibility assessment to gain an understanding of the clinical data landscape for that disease and whether a data platform would be of value to help advance research and answer critical questions.
Please note that the content has been automatically translated from English original.
There may on occasion be slight inaccuracies in this automatic translation